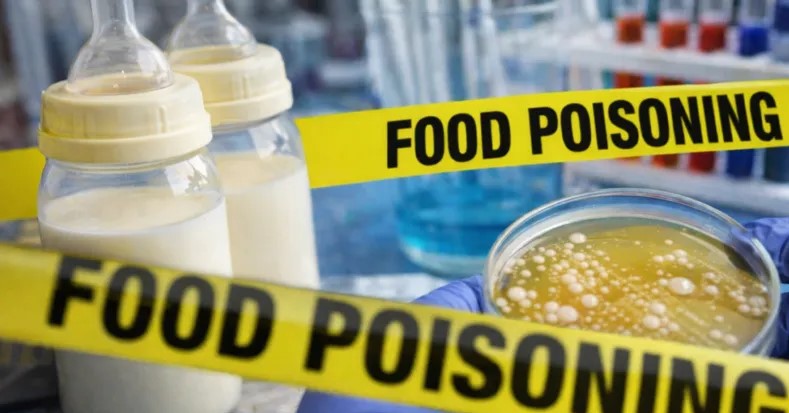
gallery

تحذير صحي.. تسمم عشرات الأطفال بحليب ملوث!
-
24 January 2026
-
4 months ago
-
-
source: Skynews
-
قال مسؤولون في مجال الصحة في الولايات المتحدة، الجمعة، إن الحليب المجفف كامل الدسم المستخدم في صناعة حليب الأطفال الذي تنتجه شركة "باي هارت"، يمكن أن يكون مصدرا للتلوث أدى إلى تفشي التسمم الغذائي الذي تعرض له العشرات من الأطفال.
وقال المسؤولون إن الاختبارات التي أجرتها إدارة الغذاء والدواء الأميركية وجدت نوعا من البكتيريا الذي يمكن أن يسبب المرض في عينتين مرتبطتين بحليب الأطفال.
ووجدت الإدارة أن البكتيريا الموجودة في علبة حليب غير مفتوحة تتطابق مع عينة من طفل مريض، كما أنها تتطابق مع التلوث المكتشف في عينات من مسحوق الحليب العضوي الكامل الدسم المستخدم في صنع حليب الأطفال في "باي هارت" والتي تم جمعها واختبارها من قبل الشركة.
كما وجدت اختبارات إدارة الغذاء والدواء تلوثا في عينة من الحليب المجفف كامل الدسم المقدم لشركة "باي هارت"، وقد تطابقت مع الجرثومة الموجودة في عينة نهائية من حليب الشركة.
وقالت الإدارة في بيان إن النتائج ليست قاطعة وإن التحقيق مستمر "لتحديد مصدر التلوث".
-
-
Just in
-
22 :51
وزارة الصحة: استشهاد سيدة وطفلتها وطفل سوري في غارة الشويفات
-
22 :44
الدوي الذي سمع صداه في بيروت وجبل لبنان منذ بعض الوقت ناتج عن قذيفة B7
-
22 :41
خاص - وزير يقترِح على "الحزب" المقايضة! تتمة
-
22 :27
"مع تقدّم العدو الاسرائيلي الى أطراف البلدة".. بيان صادر عن مركز النبطية الفوقا! تتمة
-
21 :53
حزب الله: استهدفنا تجمّعًا لآليّات وجنود جيش العدوّ الإسرائيليّ في الموقع المستحدث في بلدة العديسة بسرب من المسيّرات الانقضاضيّة
-
21 :49
وسائل إعلام إسرائيلية: قناة "i24" نيوز: محلقات حزب الله تصطاد جنودنا في لبنان وهي مسألة تكتيكية لكن لها أبعاد استراتيجية
-
-
Other stories
Just in
-
22 :51
وزارة الصحة: استشهاد سيدة وطفلتها وطفل سوري في غارة الشويفات
-
22 :44
الدوي الذي سمع صداه في بيروت وجبل لبنان منذ بعض الوقت ناتج عن قذيفة B7
-
22 :41
خاص - وزير يقترِح على "الحزب" المقايضة! تتمة
-
22 :27
"مع تقدّم العدو الاسرائيلي الى أطراف البلدة".. بيان صادر عن مركز النبطية الفوقا! تتمة
-
21 :53
حزب الله: استهدفنا تجمّعًا لآليّات وجنود جيش العدوّ الإسرائيليّ في الموقع المستحدث في بلدة العديسة بسرب من المسيّرات الانقضاضيّة
-
21 :49
وسائل إعلام إسرائيلية: قناة "i24" نيوز: محلقات حزب الله تصطاد جنودنا في لبنان وهي مسألة تكتيكية لكن لها أبعاد استراتيجية
All news
- Filter
-
-
 EXCLUSIVE
EXCLUSIVEخاص - وزير يقترِح على "الحزب" المقايضة!
-
28 May 2026
-

"مع تقدّم العدو الاسرائيلي الى أطراف البلدة".. بيان صادر عن مركز النبطية الفوقا!
-
28 May 2026
-

" إدعاء لن ينطلي على أحد".. " الحزب " يرد!
-
28 May 2026
-

إستشهاد مراسل ميداني في غارةٍ إسرائيلية!
-
28 May 2026
-

عن عمليات الاغتيال في لبنان.. هذا ما طلبته أميركا من إسرائيل!
-
28 May 2026
-

بالصور: من هم شهداء استهداف الشويفات؟
-
28 May 2026
-

بالفيديو - جنبلاط شبّه جعجع بالنبي موسى، فماذا قصد؟ ماذا نصح الذكاء الإصطناعي حاكم مصرف لبنان؟
-
28 May 2026
-

سلام يدين الاعتداءات على صور والنبطية
-
28 May 2026
-

بيان كتلة الوفاء للمقاومة: إنَّنا إذ نجدِّد رفضنا المسار التي تتبعه الحكومة بكلِّ تفاصيله!
-
28 May 2026
-
.webp)
شو الوضع؟ إنه الجحيم: اللغو الكلامي لا معنى له والجنوب يحترق والسلطة عاجزة
-
28 May 2026